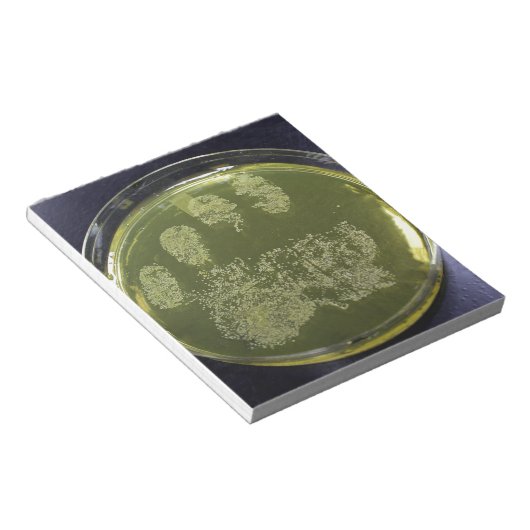
Hand Petri Dish Bacteria Notizblock (angewinkelt)

Über Notizblöcke
Verkauft von
Über dieses Design
Hand Petri Dish Bacteria Notizblock
Ein Foto Staphylococcus aureus, der auf einer Mannitolalagarplatte wächst.
Automatische Übersetzung
Kundenrezensionen
3.5 von 5 Sternen Bewertung4 Bewertungen insgesamt
4 Bewertungen
Bewertungen für ähnliche Produkte
5 von 5 Sternen Bewertung
Von Silvia D.18. Mai 2017 • Geprüfter Kauf
Bewertungsprogramm bei Zazzle
Der Notizblock gefällt mir so gut, dass ich ihn nur für ganz besondere Notizen und Nachrichten verwende. Wer eine Nachricht mit dem grinsenden Bouvier von mir bekommt, kann sich glücklich schätzen :-). Druck ist einwandfrei
Originalprodukt
4 von 5 Sternen Bewertung
Von D.22. Dezember 2012 • Geprüfter Kauf
13,97cm x 15,24cm Notizblock - 40 Seiten
Bewertungsprogramm bei Zazzle
Block kann ich weiterempfehlen. Glänzendes Papier, schòn stabil und nicht zu dünn. Genug Platz für Notizen. Die Gummierung, wo die Blàtter zusammen sind
ist etwas dünn. Blàtter sind leicht lösbar,. Der Druck ist sehr gut. Schòn gross, alles gut erkennbar und sehr naturgetreue Farben.
1 von 5 Sternen Bewertung
Von C.17. Juni 2024 • Geprüfter Kauf
27,94cm x 21,59cm Notizblock - 40 Seiten
Ich kann es nicht einschätzen, da ich das Produkt bis heute nicht erhalten habe. Kann ich nichts zu sagen, da die Lieferung bis heute nicht angekommen ist. Jegliche Versuche UPS zu kontaktieren sind fehlgeschlagen.
Tags
Andere Informationen
Produkt ID: 133442291875458341
Gemacht am: 24.12.2013, 9:11
Bewertung: G
Zuletzt angesehene Produkte